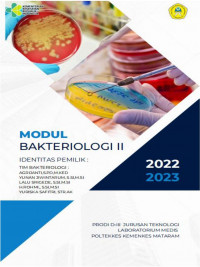
Image of MODUL PRAKTIKUM BAKTERIOLOGI II SEMESTER III

Electronic Resource
MODUL PRAKTIKUM BAKTERIOLOGI II SEMESTER III
Penilaian
0,0
dari 5Tidak Tersedia Deskripsi
Ketersediaan
#
location_name
371.3 Jiw M
E00090
Tersedia
Informasi Detail
- Judul Seri
-
-
- No. Panggil
-
371.3 Jiw M
- Penerbit
- Mataram : Poltekkes Kemenkes Mataram., 2022
- Deskripsi Fisik
-
-
- Bahasa
-
Indonesia
- ISBN/ISSN
-
-
- Klasifikasi
-
371
- Tipe Isi
-
-
- Tipe Media
-
-
- Tipe Pembawa
-
online resource
- Edisi
-
-
- Subjek
-
-
- Info Detail Spesifik
-
-
- Pernyataan Tanggungjawab
-
Yunan Jiwintarum
Versi lain/terkait
Tidak tersedia versi lain
Lampiran Berkas
Komentar
Anda harus masuk sebelum memberikan komentar
 Karya Umum
Karya Umum  Filsafat
Filsafat  Agama
Agama  Ilmu-ilmu Sosial
Ilmu-ilmu Sosial  Bahasa
Bahasa  Ilmu-ilmu Murni
Ilmu-ilmu Murni  Ilmu-ilmu Terapan
Ilmu-ilmu Terapan  Kesenian, Hiburan, dan Olahraga
Kesenian, Hiburan, dan Olahraga  Kesusastraan
Kesusastraan  Geografi dan Sejarah
Geografi dan Sejarah